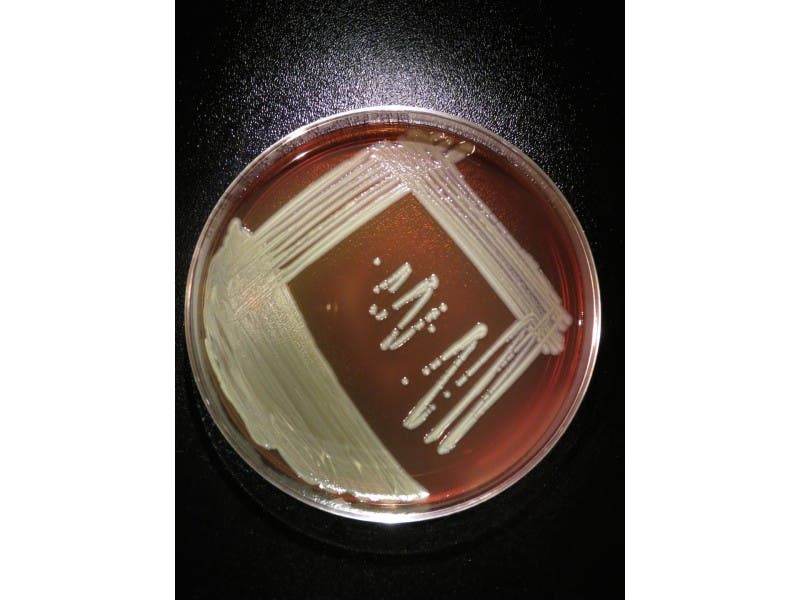

Health & Fitness
1st Illinoisan to Die of Elizabethkingia Bacteria ID'd as Lake Villa Woman
Outbreak already has claimed the lives of 18 Wisconsin residents and one Michigan resident.
The death of a 52-year-old Lake Villa woman has been linked to the bacterial infection called Elizabethkingia, which already has killed 18 people in Wisconsin and one person in Michigan, CBS Chicago reports. Kimberly Cencula of Lake Villa is the first person in Illinois to contract and die from the Elizabethkingia bacteria.
It's unclear at this point how Cencula contracted the infection, according to CBS.
Elizabethkingia is a common organism in the water and soil but it rarely causes infections, according to the Illinois Department of Public Health website. The majority of the infections identified to date in the outbreak have been bloodstream infections, but some patients have had Elizabethkingia isolated from other sites, such as their respiratory systems or joints, according to the Illinois Department of Public Health.
Find out what's happening in Grayslakefor free with the latest updates from Patch.
“Illinois is working closely with the CDC and Wisconsin and Michigan health officials to investigate this outbreak and develop ways to prevent additional infections,” said IDPH Director Nirav D. Shah, M.D., J.D. “IDPH will continue to coordinate with hospitals and health care providers to quickly identify and report cases of Elizabethkingia.”
The majority of the patients who have had Elizabethkingia infections as part of this outbreak are over 65 years of age, and all have had underlying health conditions, according to the IDPH. It has not yet been determined whether the deaths associated with this outbreak were caused by the bacterial infection, the patients’ underlying health conditions, or both.
Find out what's happening in Grayslakefor free with the latest updates from Patch.
Get Patched In
Get more local news delivered straight to your inbox. Sign up for free Patch newsletters and alerts.